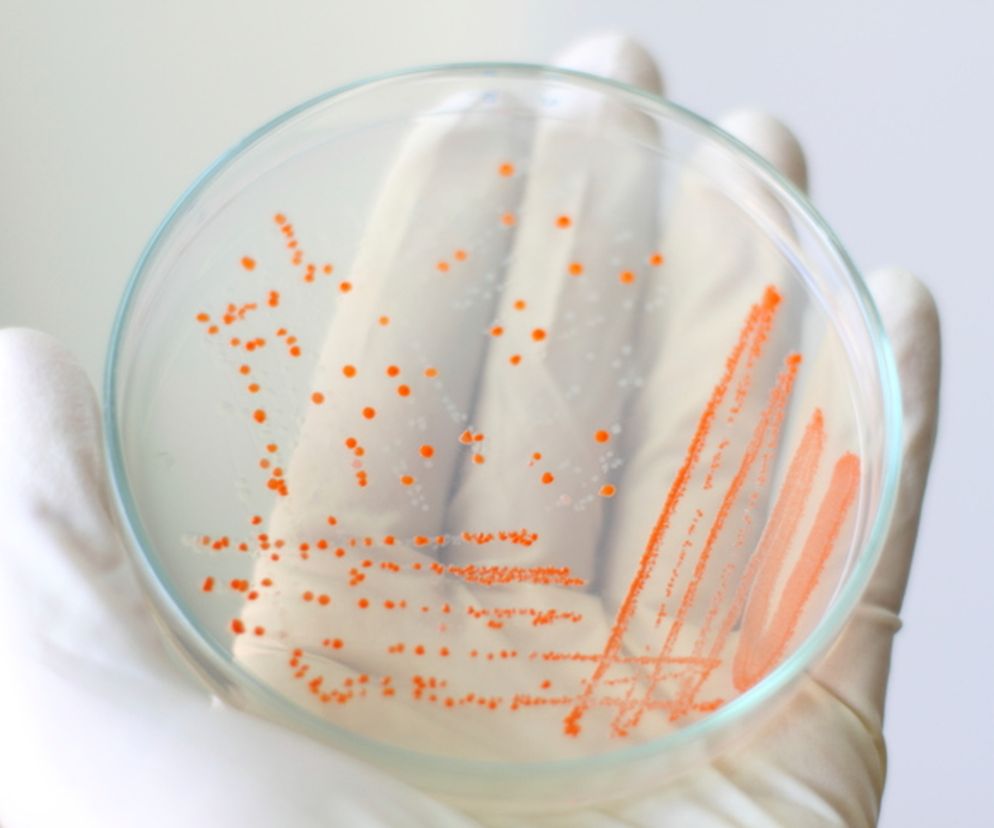

Spis treści
Helicobacter pylori to bakteria, która odpowiada za około 70 proc. przypadków choroby wrzodowej żołądka i około 95 proc. przypadków owrzodzeń dwunastnicy, a także może być przyczyną innych poważnych schorzeń układu pokarmowego, takich jak rak czy chłoniak żołądka. Aby wykryć zakażenie H. pylori i dowiedzieć się, czy istnieje ryzyko rozwoju tych chorób, należy wykonać odpowiednie testy diagnostyczne. Badania na obecność Helicobacter pylori dzieli się na badania nieinwazyjne i inwazyjne. Te ostatnie wymagają pobrania od pacjenta fragmentu błony śluzowej żołądka.
Helicobacter pylori - wskazania do badania
Wykonanie badań na obecność H. pylori jest wskazane u osób, które skarżą się m.in. na nudności, wymioty, częstą zgagę, dyskomfort po posiłku i bóle żołądka. Są to objawy sugerujące chorobę wrzodową lub inne choroby przewodu pokarmowego, za które może być odpowiedzialna bakteria H. pylori. Badania te można wykonać także u pacjentów z nawracającymi owrzodzeniami żołądka i dwunastnicy.
WARTO WIEDZIEĆ>>Wrzody żołądka uaktywniają się wiosną i jesienią
Helicobacter pylori - badania nieinwazyjne
- helicobacter pylori - test z krwi
Celem testu z krwi jest oznaczenie przeciwciał IgG skierowanych przeciw H. pylori, a także przeciwciał w klasie IgA. Normą jest ujemny wynik badania, tzn. brak przeciwciał we krwi. Ich obecność świadczy o zakażeniu.
Obecność przeciwciał we krwi potwierdza jedynie kontakt z bakterią, ale nie wskazuje na aktualne zakażenie. Tylko test z kału i oddechowy (a także testy inwazyjne) wykrywają aktualne zakażenie.
Najskuteczniejszym, nieinwazyjnym testem na obecność H. pylori jest test oddechowy. Nazywany jest "złotym standardem" w nieinwazyjnej diagnostyce zakażenia tą bakterią.
- helicobacter pylori - test z kału
- posiew kału - przeniesienie bakterii z kału na specjalne pożywki w celu ich namnażania - normą jest brak H. pylori w posiewie- test wykrywający RNA bakterii - RNA to kwasy rybonukleinowe, które stanowią materiał genetyczny bakterii. Normą jest brak RNA H. pylori- oznaczenie antygenu H. pylori w próbce kału. Normą jest ujemny wynik badania, tzn. brak obecności antygenów
CZYTAJ TEŻ >> HELICOBACTER PYLORI: bakteria, która może doprowadzić do RAKA
- helicobacter pylori - test oddechowy
Celem testu oddechowego jest zbadanie zawartości tzw. ciężkiego węgla w wydychanym powietrzu. Węgiel ten pochodzi z rozkładu mocznika przez ureazę - enzymu bakterii H. pylori, który nie występuje w żołądku osoby zdrowej.
Pierwszym etapem badania jest wydmuchanie powietrza do specjalnego worka. W drugim etapie pacjentowi podaje się do wypicia kwaśny płyn (kwasek cytrynowy lub sok pomarańczowy) oraz mocznik znakowany izotopem 13C (lub rzadziej radioizotopem 14C). Po 30 minutach pacjent ponownie wypełnia wydmuchanym powietrzem specjalny worek. Następnie mierzy się poziom węgla w obu próbkach powietrza. Prawidłowo w obu próbkach powinien być mniej więcej taki sam. Jeśli jednak w drugiej próbce doszło do podwyższenia stężenia węgla, mamy do czynienia z zakażeniem H. pylori.
Helicobacter pylori - badania inwazyjne
Badaniem inwazyjnym na obecność H. pylori jest gastroskopia. W jej trakcie można pobrać wycinki błony śluzowej żołądka do:
- badania histopatologicznego - to badanie pobranego fragmentu tkanki pod mikroskopem
- testu ureazowego (CLO-test) - pobrany wycinek błony śluzowej żołądka umieszcza się na specjalnym krążku, który zawiera mocznik oraz barwnik. Ten ostatni zmienia kolor w wyniku rozkładu mocznika przez ureazę – enzym produkowany przez H. pylori. Zmiana zabarwienia potwierdza obecność ureazy, a tym samym bakterii H. pylori.
Porady eksperta
Bakteria Helicobacter pylori często jest rozmieszona w żołądku i/lub dwunastnicy dość nieregularne. Natomiast wycinek błony śluzowej żołądka pobierany podczas gastroskopii jest bardzo mały, dlatego istnieje ryzyko, że w danym wycinku nie stwierdzi się obecności bakterii, mimo że bytuje ona w żołądku i/lub dwunastnicy.